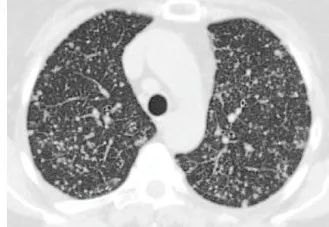
图片
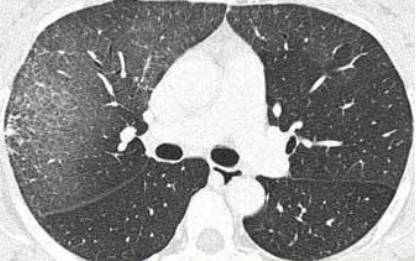
图片

肺部出现「暴风雪征」,警惕以下这 5 种情况!
2024年9月21日
胸片和胸部 CT 也常常显示暴风雪样外观(snowstorm appearance)或暴风雪征(snowstorm sign)这一特殊影像学征象。那么,穿越肺野的「暴风雪」究竟见于哪些疾病呢?以下为大家展现其庐山真面目。
- 结核(TB)、粟粒性结核、播散性结核、分枝杆菌菌血症
- 随机分布的无数小的非钙化性结节:不同于感染的支气管内播散结核杆菌形成结节的树芽征
典型的粟粒性病变在血源性播散3-6周前平片可能观察不到- 粟粒性结核类似其他许多疾病:高度怀疑此病对早期诊断及治疗十分重要
粟粒性结核亦可见于膀胱移行细胞癌的膀胱内卡介苗免疫治疗后- 若未治疗死亡率为100%;若早期和恰当治疗,死亡率<10%
肺内弥漫随机分布的粟粒性结节,2-3mm大小,结节与邻近的血管大小几乎相同。放大的平片示模糊的弥漫性结节,同一病例CT示随机分布的针尖大小的微小结节。肺底的容易被忽略,重建可以增加粟粒性肺结节的可见度。散在磨玻璃影背景内的粟粒性结节,胸腔少量积液,纵隔淋巴结肿大,边缘强化。膀胱移行细胞癌患者,由膀胱内的卡介苗免疫治疗引起的粟粒性肺结核,实际上是卡介苗所致的结核菌血症。- 粟粒表现的常见转移:甲状腺癌、黑色素瘤、绒毛膜癌、肾细胞癌、乳腺癌
- 转移性结节通常较粟粒性结核的结节稍大,边界更清晰,大小较粟粒性结核的结节差别更大
影像学上,肺转移瘤的特点是随机分布着形状和大小不一的结节,当患者表现为大量粟粒样小结节时称为暴风雪征,当转移灶直径较大且轮廓清晰时,则称为炮弹样病变,后者通常与胃肠道和泌尿生殖系统肿瘤有关 [2]。![图片]()
肺转移瘤患者的肺部 CT 示暴风雪征 [2]对于既往史提示患有原发性恶性肿瘤的患者,当双肺可见粟粒样或暴风雪外观的细小结节影,则强烈提示为肺转移瘤。与该影像学征象有关的常见原发性肿瘤包括甲状腺癌、恶性黑色素瘤、肾细胞癌、乳腺癌以及胰腺癌等胃肠道恶性肿瘤,其组织类型常见腺癌或肉瘤 [2-3]。Al-Thuhli H 和 Al-Futaisi A 曾报道这样一则案例:一位因进行性呼吸困难 6 个月入院的 23 岁女性,胸片和胸部 CT 示双肺弥漫性粟粒性结节。放射性碘 131 扫描可见甲状腺、颈部淋巴结摄取增加,伴双肺弥漫性摄取增加。病理学证实为甲状腺乳头状癌伴弥漫性肺转移 [4]。23 岁女性胸片、胸部 CT、放射性碘 131 扫描示甲状腺乳头状癌伴弥漫性肺转移 [4]值得一提的是,恶性黑色素瘤常见肺转移。在一项早期研究中,在伴有胸腔内播散的恶性黑色素瘤患者中,90% 存在肺转移,其中多结节性肺转移最为常见。与其他肺转移征象相比,具有暴风雪样外观的患者预后不佳 [5]。例如,以下是一位恶性黑色素瘤患者的胸片,18 个月前仅有缓慢增大的单发结节,随访观察后结节增多并进展至暴风雪样外观,患者出现该征象 6 周后死亡 [5]。![图片]()
一位恶性黑色素瘤患者的胸片呈暴风雪样外观 [5]许多恶性肿瘤患者的化疗方案中包括免疫抑制剂,因此可能并发机会性感染,除了上述粟粒性肺结核,组织胞浆菌病、球孢子菌病和芽生菌病等真菌感染亦可引起暴风雪样外观 [3]。因此对于已知恶性肿瘤的患者,不能先入为主认为肺部病变就是肺转移瘤,仍需对引起暴风雪征的「幕后黑手」进行仔细排查,以除外机会性感染。如以下胸部 CT 所示,双肺野亦可见典型的暴风雪征,这是由荚膜组织胞浆菌引起的组织胞浆菌病 [6]。![图片]()
一例组织胞浆菌病患者的胸部 CT 示暴风雪征;痰标本甲胺银染色可见荚膜组织胞浆菌 [6]肺泡微结石症(Pulmonary alveolar microlithiasis)是一种病因未明的罕见肺部疾病,大多数患者的发病年龄为 20~50 岁,大约 50% 有家族史。患者多以非特异性呼吸系统症状(如干咳、呼吸困难)起病,目前该病尚无根治方法 [7]。Bhalotra B 等曾报道一例咳嗽 1 个月和间歇性发热的 28 岁男性,其胸片可见双肺野弥漫性微小结节影,胸部 CT 可见肺泡腔内有微小结石影,呈暴风雪样外观,最终诊断为肺泡微结石症 [7]。![图片]()
28 岁男性肺泡微结石症患者的胸部 CT 示肺泡腔内有微小结石影 [7]脂肪栓塞(Fat embolism)为循环血流中出现脂肪滴阻塞小血管。脂肪栓塞的栓子常来源于长骨骨折、脂肪组织严重挫伤和烧伤,这些损伤可导致脂肪细胞破裂和释出脂滴,由破裂的骨髓血管窦状隙或静脉进入血循环引起脂肪栓塞。脂肪肝时,由于上腹部猛烈挤压、撞击,使肝细胞破裂释出脂滴进入血流。在非创伤性的疾病如糖尿病、酗酒和慢性胰腺炎血脂过高或精神受激烈刺激,过度紧张使呈悬乳状态的血脂不能保持稳定而游离并互相融合形成脂肪滴。创伤性脂肪栓塞时,脂肪栓子从静脉入右心,再到达肺,直径大于20mm的脂滴栓子引起肺动脉分支、小动脉或毛细血管的栓塞;直径小于20mm的脂滴栓子可通过肺泡壁毛细血管经肺静脉至左心达体循环的分支,引起全身多器官的栓塞,最常阻塞脑的血管,引起脑水肿和血管周围点状出血。少量脂肪栓塞组织和器官可无肉眼变化,仅在组织的冰冻切片脂肪染色时始见小血管腔内有脂滴。
临床表现上,在损伤后1~3天内出现突然发作性的呼吸急促,呼吸困难和心动过速。从脂滴释出的游离脂肪酸还能引起局部中毒,损伤内皮细胞,出现特征性的淤斑皮疹,也可能与血小板粘附在脂滴上,数量迅速减少有关。脑脂肪栓塞引起的神经症状包括兴奋、烦燥不安、谵妄和昏迷等。
骨折时,由于创伤的应激作用,使正常血液的乳糜微粒失去乳化稳定性,结合成大颗粒脂肪球而成为栓子,阻塞肺毛细血管,刺激血管内皮细胞,使其脂酶释放,在脂酶作用下,中性脂滴被水解成游离脂肪酸(FFA)和甘油。被阻塞的肺血管受FFA的毒性刺激,而发生中毒性或化学性血管炎;使血管内皮细胞肿胀起疱变形,并与基膜分离,从而破坏了血管内皮细胞的完整性,使其渗透性增高,血液外渗,致肺泡内充满泡沫血性液体,发生弥漫性间质性肺水肿和急性肺泡性水肿,引起化学性和出血性肺炎,因而严重干扰肺泡膜的换气功能;由于肺泡腔内积存渗出液,肺泡表面活性物质受到破坏,而使肺的顺应性下降,最后出现动脉血低氧血症。而较小的脂肪小滴可通过肺进人体循环,引起视网膜、皮肤、脑和肾等栓塞,并经肾脏排出。
早期两肺散在性斑片状高密度,边缘模糊。严重时两肺广泛分布斑片状或者融合性大片高密度,边缘模糊,呈“暴风雪”样改变。
病例1:女性45岁,外伤史,上肢及躯干出现多个瘀点,呼吸困难。病例2:男性,18岁,骑摩托车摔伤,近日出现癫痫。其他可能引起暴风雪征的疾病包括结节病、热带嗜酸性粒细胞增多症、嗜酸性肉芽肿、胸部高速子弹伤、水痘病毒感染灶钙化等 [4,8-11]。例如,以下是步枪所致胸部高速子弹伤患者的胸片,从中可见散布在左半侧胸腔的多个点状不规则的子弹碎片 [9]。![图片]()
步枪所致胸部高速子弹伤患者的胸片 [9]由于有时弥漫性肺部小结节的体积太小,仅通过胸片来发现和评估其形态特征可能并非易事,尤其直径仅 1~2 mm 的结节在胸片中「若隐若现」,可能需要进行 HRCT 来进一步明确。结节边缘的形态是进行影像学鉴别诊断的重要标准。如果结节界限不清,则更可能是远端气道受累(腺泡结节),此时应考虑引起肺泡水肿、渗出或出血的疾病。另一方面,如果结节影的界限清晰,提示这些结节更可能是间质性病变,则应考虑结节病、嗜酸性肉芽肿等疾病 [11]。综上所述,胸片和胸部 CT 中穿越肺野的暴风雪样外观或暴风雪征与感染(粟粒性肺结核、真菌感染)、肺转移瘤、肺泡微结石症、肺脂肪栓塞、结节病、热带嗜酸性粒细胞增多症、嗜酸性肉芽肿等疾病有关。结节边缘的形态特征可能有助于提示病变性质。
来源:上术呼吸
编辑:Yan